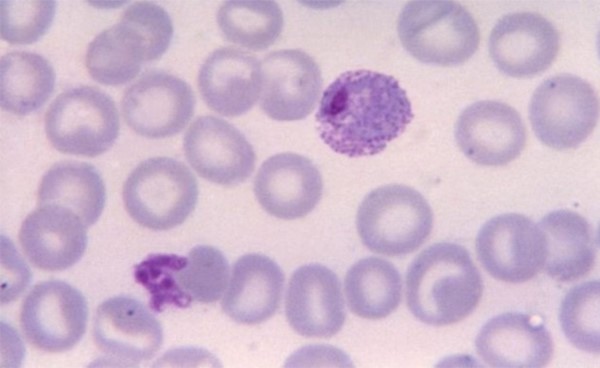

النجاح في تكوين أكثر الخلايا البشرية “شبابية” على الإطلاق في المختبر
نجح فريق دولي يقوده علماء صينيون في إنتاج أكثر الخلايا البشرية “شبابية” على الإطلاق في المختبر، وهو ما قد يمهد الطريق لتحقيق تقدمات في تجديد الأعضاء.
وأعلنت الدراسة التي نشرت يوم الثلاثاء في مجلة “نيتشر”، عن اكتشاف طريقة سريعة ويمكن التحكم فيها لتحويل خلايا جذعية إلى خلايا حقيقية شبيهة بالجنين المؤلف من ثماني خلايا، دون الاعتماد على الهندسة الوراثية.
وقام فريق من الباحثين من الصين وبريطانيا وبنجلاديش بتحويل خلايا جذعية متعددة القدرات، أو نسخة “بالغة” من خلايا جنينية أولية، إلى نسخة أكثر “شبابية” من الخلايا ذات القدرات التنموية، تشبه البويضات المخصبة في يومها الثالث من مرحلة النمو.
وتعمل الخلايا كاملة القدرات الشبيهة بالجنين المكون من ثماني خلايا، على إعادة تكوين الحالة الجنينية للبويضة الملقحة بعد ثلاثة انقسامات فقط، ما يجعلها أكثر الخلايا البشرية “شبابية” على الإطلاق التي يتم تخليقها في المختبر، وفق ما ذكر لي ون جيوان، من الأكاديمية الصينية للعلوم، وهو وأحد المؤلفين المراسلين للدراسة.
وتعني الخلايا “كاملة القدرات” أنها قادرة على تخليق جميع أنواع الخلايا داخل أنسجة جنينية أو داخل أنسجة خارج الجنين، بحسب ما أوضح الباحثون.
وقال لي “هذه الخلايا لا يمكنها التمايز إلى أنسجة مشيمية فحسب، بل يمكنها أيضا التطور إلى أعضاء أكثر نضجا”.
وبحسب الدراسة فإن الباحثين زرعوا أيضا خلايا المرحلة المكونة من ثماني خلايا تحت جلد فئران بالغة، حيث تطورت هذه الخلايا إلى أورام مسخية معقدة.
وتم تسهيل هذه التجربة من خلال تقنية التسلسل أحادي الخلية التي طورتها “بي.جي.آي-ريسيرش” التي مقرها مدينة شنتشن. ومَنحت المراجعة الأخلاقية الموافقة للدراسة المعنية.















